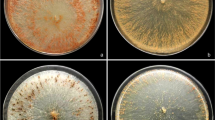

Abstract
Dichlorophenoxyacetic acid (2,4-D) is one of the most commonly used weed control herbicides. White-rot fungi (WRF) are recognized as a degrader of a wide range of molecules because due to their enzymatic plasticity, nevertheless, the knowledge of their ability to degrade 2,4 D residues in the environment is still limited. In this study, the tolerance and the mycelium growth kinetics of twelve WRF to 2,4-D (670 g L−1) were evaluated on potato dextrose agar added with 2,4-D using the technique of cup plate. Agaricus sp., Pleurotus pulmonarius, Pleurotus djamor and the EF 58 strain grew in all plates in the presence of 2,4-D. Molecular phylogenetic analysis of the EF 58 strain allowed its determination as a lineage belonging to Lentinus crinitus Fr. (Polyporales, Basidiomycota) species-complex. The daily fungal growth rate of L. crinitus EF 58 lineage in medium with (5.025 g L−1 and 50.25 g L−1) and without the addition of the herbicide, laccase production and mycelium structure after 6, 10 and 15 days of exposure to 2,4-D was analyzed. There were no significant differences between the control and C1 treatments concerning the growth of L. crinitus EF 58 lineage. The enzymatic activity tests showed evidence for the presence of laccases in all essays. Optical microscopy observations did not reveal substantial alterations in its mycelium morphology after exposition to the herbicide. It was the first study showing the potential of L. crinitus EF58 lineage in tolerating 2,4-D what represents the beginning of work for the bioremediation process with practical applications.
Similar content being viewed by others
Explore related subjects
Discover the latest articles, news and stories from top researchers in related subjects.Avoid common mistakes on your manuscript.
Introduction
Agriculture is a crucial issue in the environmental debate as food production, and other agricultural products absorb 70% of the world’s freshwater (UN 2018). In agriculture, in addition to high water consumption, the generation and disposal of effluents, without proper treatment, constitute a significant challenge in the context of rural sanitation. The negative effects of pesticides on health of humans and in the environment are increasingly worrying (Mahmood et al. 2016; Baumgartner et al. 2017; Budzinski and Couderchet 2018). Despite the international initiatives to discuss and mitigate the problem associated with pesticides, it receives less attention than necessary, such as the contribution of agriculture to water pollution (FAO 2018). The studies to evaluate the presence of agrochemicals in waters used for irrigation and, in turn, the possibilities of treatment of these effluents, aiming at the degradation of these contaminants, are still scarce.
Among the agrochemicals used in agriculture, 2,4-D stands out as the first organic herbicide synthesized in the 1940s (Ahlborg and Thunberg 1980) and is one of the most commonly used products for weed control (Schulz and Segobye 2016; Hiran and Kumar 2017).
On the other hand, this compound forms highly toxic metabolic intermediates (Ditzelmüller et al. 1989; Short et al. 1991; Bukowska 2003; Lurquin 2016; Wang et al. 2015). The European Commission (EC) regulates pesticides in drinking water by the Drinking Water Directive (DWD) using a maximum allowable concentration of 0.1 µg L−1 (DWD 1998). In Brazil, the guideline values for chemicals from agricultural activities of health significance in drinking water (Brazilian Ordinance from Ministry of Health No. 2914/2011) define a concentration of 30 µg L−1 for 2,4-D as a maximum allowable value (Brazil 2011).
Many microorganisms that act on 2,4-D degradation have been isolated in different environments around the world. However, most studies have emphasized the role of 2,4-D degrading bacteria and not in the corresponding fungi with this ability (Fournier and Catroux 1980; Vroumsia et al. 2005; Singh 2006; Zabaloy et al. 2008; Ferreira-Guedes et al. 2012; Itoh et al. 2013). The screening of white-rot fungi (WRF) for tolerance to single and mixtures of pesticides in vitro is useful to identify possible candidates of active bioremediation applications (Magan et al. 2010). WRF can efficiently degrade many chlorinated organic contaminants, including 2,4-D (Gianfreda and Rao 2004; Pizzul et al. 2009; Gaitan et al. 2011; Jin et al. 2016). Although there are some advances in studies about its degradation, there are still many reports of poisoning cases, histopathological changes, genotoxicity, mutagenicity and carcinogenicity, among other abnormalities including death of humans and animals (Dakhakhni et al. 2016, Hiran and Kumar 2017, Islam et al. 2018).
Many studies related to the potential of Basidiomycota aim at producing compounds of nutritional (Henriques et al. 2008, 2016; Stevanovic et al. 2018), pharmacological and medicinal (Qi et al. 2016; Singdevsachan et al. 2017; Tang and Zhong 2004; Kozarski et al. 2011) utility. Numerous investigations about the biodegradation of xenobiotics by fungi have focused on the discoloration of industrial effluents (Jarosz-Wilkołazka et al. 2002; Machado et al. 2005; Kalmiş et al. 2007; Gomes et al. 2009; Manzano-León et al. 2011; Yildirim et al. 2012; dos Santos Bazanella et al. 2013; Al-Ghamdi 2016; Chicatto et al. 2018) and recuperation of heavy metal-contaminated soils (Adenipekun et al. 2011; Dulay et al. 2015) and also persistent organic pollutants (Erguven and Yildirim 2019). For more than 20 years, degradation studies of chlorinated compounds have been carried out with microorganisms from different orders (Erguven 2018). Studies about accumulation and persistence of many chlorinated aromatics in the environment become necessary for the comprehension of biochemical processes for its mineralization (Serbent et al. 2019). Although the WRF potential in bioremediation processes is still far from being fully explored, we have chosen fungi with and without previous studies about their ability to degrade chlorinated compounds.
Agaricales is one of the most diverse orders of the phylum Basidiomycota and has several prominent members, including the genera Agaricus L., Lentinula Earle, Macrocybe Pegler and Lodge, Pleurotus (Fr.) P. Kumm. that grow in a wide variety of habitats (Money 2016).
Pleurotus pulmonarius (Fr.) Quél. was the first WRF used in biodegradation studies of chlorinated compounds in liquid culture, more than two decades ago (Masaphy et al. 1993), demonstrating that the fungus ability to dealkylate and hydroxylate atrazine was not dependent on previous incubation with the compound and that the degradation biochemical pathway occurred via the constitutive metabolic activities of natural molecules. A contemporary investigation (Okeke et al. 1993) showed the aerobic metabolism of pentachlorophenol (PCP) by Lentinula edodes (Berk.) Pegler in soils and demonstrated the competitive advantage of this fungus to eliminating both PCP and pentachloroanisole when compared to mixed culture with indigenous Funga (Kuhar et al. 2018) of soils contaminated. The ability of the Agaricales P. pulmonarius, L. edodes, and the Polyporales Ganoderma lucidum (Curtis) P. Karst. to remove PCP was demonstrated by Chiu et al. (1998) using a batch cultivation system. In relation to another chlorine compound, 2,4-dichlorophenol (2,4-DCP, primary metabolite from 2,4-D transformation), the rapid oxidation was associated with laccase (60% transformation after 6 h) and versatile peroxidase (100% transformation after 1 h) of P. pulmonarius (Rodriguez et al. 2004), while the role of laccase in PCP removal was confirmed by Souza et al. (2011) in submerged cultures of P. pulmonarius.
On the other hand, the degradation of 2,4-DCP through L. edodes laccase and Mn-peroxidase production was demonstrated by Tsujiyama et al. (2013). In a more recent study, Gąsecka et al. (2015) established the degradation of polychlorinated biphenyls (PCBs) by L. edodes and Agaricus sp. To a single PCB (28 chlorine atoms), they reported degradations between 7.38 ± 1.06–75.30 ± 1.46% and 31.32 ± 1.52–83.91 ± 1.07%, respectively, after 12 weeks of incubation. Complementary applications for L. edodes to the removal of heavy metals as cadmium have been reported in recent decades (Chen et al. 2006; Qiao et al. 2014).
Most published research with Agaricus brasiliensis Fr. has focused on their properties as a diet supplement in human nutrition (Henriques et al. 2008, 2016; Stevanovic et al. 2018) and in their antioxidative and immunomodulating activities (Tang and Zhong 2004; Henriques et al. 2008; Kozarski et al. 2011; Henriques et al. 2016; Stevanovic et al. 2018).
Macrocybe titans (H.E. Bigelow and Kimbr.) Pegler, Lodge and Nakasone strains have been used for the biodegradation of food industry waste (Wisniewski et al. 2010; Zilly et al. 2012) as long as Pleurotus djamor (Rumph. ex Fr.) Boedijn, another member of Agaricales order, has been studied because of their antioxidant potentials (Sasidhara and Thirunalasundari 2014) and their decolorizing mechanisms (Kalmiş et al. 2007; Manzano-León et al. 2011; Yildirim et al. 2012; Duarte et al. 2014) and, also, as an alternative for the treatment of water containing recalcitrant pharmaceuticals (Mayorga et al. 2017).
Inonotus splitgerberi (Mont.) Ryvarden, another of the species studied in this work, have been mostly studied about ecological aspects as habitat preferences, communities, demographics, diversities, and distributions (Thaung 2007). The antioxidative and immunomodulatory activity, as well as an alternative treatment of cancer, was demonstrated in Tropicoporus linteus (Berk. and M.A. Curtis) L.W. Zhou and Y.C. Dai, another member of the Hymenochaetales group (Sliva 2010; Huang et al. 2010, 2011; Kozarski et al. 2011).
As dominant wood-decay fungi, species of Polyporales are of interest to both fungal ecologists and applied scientists (Justo et al. 2017). Although that most studies with G. lucidum are related to its medicinal (Kozarski et al. 2011, Tang and Zhong 2004) and pharmacological properties (Boh et al. 2007; Ćilerdžić et al. 2017; Barbieri et al. 2017; Chen and Lan 2018; Ghobadi et al. 2018; Zhao and He 2018), recent works have explored the use of this fungus or its enzymes to degrade organic compounds xenobiotics (Gąsecka et al. 2015; Coelho-Moreira et al. 2018). In respect of organochlorine compounds, the efficiency of G. lucidum in the bioconversion of diuron (Da Silva Coelho et al. 2010; Coelho-Moreira et al. 2018), bentazon (Da Silva Coelho et al. 2010) and pentachlorophenol (PCP) (Jeon et al. 2008) had been shown.
Ganoderma applanatum (Pers.) Pat. is a widely distributed wood-decaying species whose ligninolytic enzyme system has not been sufficiently studied (Ćilerdžić et al. 2016, 2017). There are reports about their capacity for degradation of dyes used in textile industries (Jarosz-Wilkołazka et al. 2002; Al-Ghamdi 2016). Regarding pesticide bioconversion, the organochlorine-degrading capabilities of G. lucidum associated with the enzymatic mechanism for diuron (Da Silva Coelho et al. 2010; Coelho-Moreira et al. 2018) and lindane (Kaur et al. 2016) have shown the potential of this species for managing organochlorine bioremediation at contaminated sites.
Medicinal properties of Polyporus lipsiensis (Batsch) E.H.L. Krause include anti-tumor (Qi et al. 2016), antioxidant and anti-bacterial activity (Singdevsachan et al. 2017). Nevertheless, the decolorization activity has been attributed to P. lipsiensis strains isolated from a tropical ecosystem (Machado et al. 2005).
Previous studies with the Australasian–South American fungus Tyromyces pulcherrimus (Rodway) G. Cunn. evaluated their role in the decomposition of indigenous coarse woody debris as well as explored their ecological aspects (Hood et al. 2008; Westphalen and Silveira 2013).
Finally, the genus Lentinus Fr. belongs to Polyporaceae and presents several species widely distributed throughout the world (Pegler 1983). Many of them have already been used to produce compounds of nutritional, pharmacological and medical interest (Attarat and Phermthai 2014; Dulay et al. 2015; Sharma et al. 2015; Umeo et al. 2015), industrial enzymatic applications (Kirsch et al. 2011, 2013; Petchluan et al. 2014; Tahir et al. 2013; Valle et al. 2014) including the absorption capacity of heavy metals (Bayramoglu et al. 2002; Yakup Arica and Bayramoglu 2005), the treatment of organic solid (Kabbashi et al. 2014; Adebayo et al. 2015; Nitayapat et al. 2015) and the decolorization capability (Machado et al. 2005; Niebisch et al. 2010). The decolorization efficiency by L. crinitus (L.) Fr. isolates was previously reported (Machado et al. 2005; Moreira Neto et al. 2009; Niebisch et al. 2010).
In fungi, the agar-plate culture system has been used in enzymatic activity assays (Adebayo et al. 2015; Cambri et al. 2016) and for the isolation and characterization of strains with potential for the degradation of organochlorine compounds (Silva et al. 2007; Sing et al. 2014; Carascal et al. 2017; Wang et al. 2017; Erguven and Koçak 2019; Erguven and Demir 2019).
In order to deepen the understanding of the degradation of 2,4 D, studies were carried out in which 12 species of WRF were first tested due to their ability to grow in an agar-plate culture system with the herbicide. Afterward, growth, enzymatic activity and morphological structure in response to the 2,4-D of the fungus L. crinitus EF 58 lineage, selected in the previous step, was determined. Due to the characteristics of WRF, the purpose of the present study was to evaluate the potential use of Basidiomycota fungi as degradation agents of 2,4-D by assessing their tolerance and growth in an agar-plate culture system with this herbicide.
Materials and methods
Organisms and culture system
Twelve fungi (Table 1) with and without reports in the literature about the ability to degrade organochlorine compounds were tested for their tolerance to 2,4-D by the addition of this pure herbicide in agar-plate culture system (PDA—potato dextrose agar with bacteriological peptone 0.1% and malt extract 1%). The EMBRAPA Forests Collection/EF (Brazil) provided the species/strains except for Ganoderma sp., acquired by the Collection of Cultures of the São Paulo Botanical Institute/CCIBT (Brazil), used for this study.
Preliminary screening for 2,4-D herbicide tolerance
Sterile microbiological dishes were prepared with 20 mL of culture medium and kept in a sterile laminar flow chamber under UV light until culture medium solidification. 2,4-D herbicide solution (670 g L−1) was sterilized by filtration through 0.45-µm-pore size Millipore membranes and added on the surface of the medium to a final volume of 100 μL and spread with the help of a sterile Drigalski spatula (Reis et al. 2013). A five-millimeter mycelial disk of each fungus was placed mycelium facedown on the center of the agar plates with and without prior application of 2,4-D (control test). All assays were performed in triplicate.
The dishes were incubated in a BOD chamber at 27 °C ± 1 °C for 14 days (approximate time in which the control occupied the entire surface of the culture medium). After that period, measurements of single-position central mycelial diameter were taken with digital pachymeter (Digimess). Daily fungal growth rate (DGR) was calculated for each fungal colony by using Eq. 1 (Venâncio et al. 2017):
and expressed as cm day−1, where Db is the average of the two measured diameters at the end of the assay, Da is the diameter of the disk at the beginning of the assay (0.5 cm) and tb − ta is the exposure time interval (in days).
Due to its capability of growth on agar plates supplemented with 100 µL of 2,4-D at 670 g L−1 (acid equivalent in the commercial solution), the EF 58 strain was selected for the following assays with the concentration used in the field (C1): 5.025 g L−1—1.5 L of commercial solution and 198.5 L of water—(Cupul et al. 2014) and with 10 times the concentration used in the field (Sapieha-Waszkiewicz et al. 2003) (C2): 50.25 g L−1. The control plates contain only the fungus without 2,4-D addition. The average diameter of the EF 58 mycelium was daily measured with digital pachymeter (Digimess) until the plate was completely covered and the mycelial diameter growth rate was calculated. For this, two perpendiculars to one another straight lines were marked on the bottom of each microbiology dish. The crossing point matched with the center of the 5-mm initial mycelial pellet, and measurements were recorded daily from the edge of the initial fungi disk until the last area of fungi mycelia development, following the segments formed by the perpendicular lines (Miyashira et al. 2010).
DNA isolation, PCR and sequencing methods
Genomic DNA was isolated from the EF 58 culture using a CTAB protocol (Góes-Neto et al. 2005). Internal transcribed spacer (ITS) DNA region was amplified in this study with primers ITS6R and ITS8F (Dentinger et al. 2010). PCR products were purified according to the protocol with polyethylene glycol (PEG) (Sambrook et al. 1989). The sequencing of markers was by capillary electrophoresis in the ABI3730 apparatus using POP7 polymer and BigDye v3.1 at Myleus Biotechnology (www.myleus.com).
Sequence alignment and phylogenetic analyses
The chromatograms were edited manually in Geneious software version 9.0.5 (Kearse et al. 2012), and subsequently, the sequences obtained were compared with those most similar deposited in GenBank, through the BLASTn tool. The sequences were aligned in MAFFT v.7 (Katoh and Standley 2013) and later edited manually by MEGA software v.7 (Kumar et al. 2016). Maximum likelihood (ML) methods with 1000 pseudoreplications (bootstrap) and Bayesian inference (IB) were used for the construction and analysis of the phylogenetic trees using RAxML version 8.2.10 (Stamatakis 2014) and Mr. Bayes v. 3.2.6 (Ronquist et al. 2012) software, respectively. The most suitable molecular evolution model for the data was obtained through the jModelTest2 v.2.1.6 using the Akaike information criterion (AIC) (Posada and Buckley 2004). The programs were used by the CIPRES platform (https://www.phylo.org/) (Miller et al. 2010). The ML analysis involved 100 searches, each from a random step-by-step addition tree, under the GTRGAMMA model, with no proportion of invariant sites and all other parameters estimated by the software. After obtaining the final topologies of ML and IB, their congruences were evaluated visually, being considered incongruent only clades with a different configuration that presented significant support, and in all cases, ML topology was selected, and IB values were recorded. Polyporus dictyopus Mont. was chosen as out-group*. The tree was edited in the program FigTree® v1.4.0. Access numbers for generated sequencing and additional sequence information analyzed are listed in Table S1 (Supplementary methods).
Kinetics of Laccase production
After 6, 10 and 15 days, samples from mycelium of the culture medium with and without 2,4-D were re-cultured by introducing a 7-mm Ø disk (of each fungus mycelium in each treatment) in new microbiological dishes (90 mm Ø) with freshly prepared agar-malt medium with 0.5% (m/v) gallic acid described by Davidson et al. (1938). The pH was corrected to 5.5 with 5% NaOH. The assays were performed in duplicate. Laccase production was accompanied by the oxidation of the substrate, resulting in halo formation that was measured daily for 5 days. The tolerance assays and daily growth measures were conducted at Laboratory of Biomass Engineering (LEBIO) in Regional University of Blumenau (FURB).
Morphological analysis
To verify noticeable changes in the morphology when fungi growth in the presence of the herbicide, mycelia of the 2,4-D-tolerant EF 58 strain from the agar medium (control and 2,4-D supplemented agar plates) were examined by optical microscopy. Slides were fixed using the cotton blue and floxin to dye and with distilled water and observed under an optical microscope. Fragments of the aerial and submerged mycelia in both, center and borders, were fixed in 3.0% KOH and examined by light microscopy. Floxin (1% aq.) was used for staining the material. Counting and characterization of microstructures were made to a comparison of treatments, with and without 2,4-D addition. The measurements (n = 15) of the structure’s sizes (hyphae and chlamydospores) were taken considering the variations in the type of treatment: without (Control) and with herbicide (C1 and C2); time of exposure (5, 10 and 15 days) and location of the mycelium (horizontal: center/edge and vertical: aerial/submerged). Also, chlamydospores shape was classified based on the Q-range intervals Stalpers (2007). The microscopical observations were conducted at Laboratory of Mycology at Federal University of Santa Catarina (UFSC) and Laboratory of Parasitology at Regional University of Blumenau (FURB).
Statistical analysis
Student’s T test was used to evaluate significant differences of fungal growth rates and laccase production of EF 58 strain between the different treatments from the daily measurements of the colonies’ diameter and the halos of the oxidation reaction of gallic (Atri and Sharma 2011; Sharma and Atri 2013). We used the nonparametric Kruskal–Wallis test to compare the caliber of the generative hyphae and the chlamydospores sizes in different treatments and exposition times (Ellegaard-Jensen et al. 2013; Wang et al. 2017).
Results and discussion
WRF tolerance to 2,4-D
The tolerance of the fungi to the 2,4-D herbicide was evaluated for their ability to grow on solid medium added with 100 μL of 2,4 D herbicide solution. Table 2 shows the diametral mycelial growth (mean value) of the 12 fungi used in the screening test after 14 days of cultivation (initial mycelial pellet of 0.5 cm) in the presence and absence of the herbicide. For species Pleurotus pulmonarius, Pleurotus djamor, EF 58, and Agaricus sp. mycelial growth were observed in all microbiological dishes (triplicates) in the presence of 2,4-D showing tolerance to this herbicide.
The growth of Agaricus sp. [a, b], Lentinus strigellus [c, d], Pleurotus djamor [e, f] and Pleurotus pulmonarius [g, h] after 14d in medium without and with 2,4-D, respectively, is shown in Fig. 1. Mycelial growth in all plates showing tolerance to this herbicide was observed (Fig. 1b, d, f, h). Mycelial growth was higher (T test p < 0.05) in the absence of herbicide when compared to the control test (Fig. 1a, c, e, g). Agaricus brasilensis [i, j], Ganoderma applanatum [k, l], Polyporus lipsiensis [m, n], Ganoderma lucidum [o, p], Inonotus splitgerberi [q, r], Macrocybes titans [s, t], Tropicoporus linteus [u, v], and Tyromyces pulcherrimus [w, x] did not present mycelial growth, indicating a negative response to the 2,4-D tolerance test (Fig. 1).
The rule shows the size of the petri dish (9 cm).
Among the WRF tested, Lentinus strigellus EF 58 was selected for subsequent trials due to its tolerance to 2,4-D (670 g L−1). Atypical characteristics (absence of clamp connection on generative hyphae) of Lentinus were observed in the strain in the mycelium of Lentinus strigellus EF 58. For that reason, the molecular identification of the strain under study was carried out. A matrix containing in-group sequences of Polyporaceae genera was previously assembled to confirm the positioning of the strains in the family and to confirm the genus Lentinus. After the result of the analysis, a second matrix with the in-group species of Lentinus was created in order to phylogenetically determine the position of EF58 strains. The topologies of phylogenetic trees based on the dataset generated from Bayes and RAxML analyses are identical. Therefore, only the ML tree with bootstrap values (BS) is shown in Fig. 2, with Bayesian posterior probabilities (BPPs) also indicated. The best evolutionary model estimated using the AIC for ITS was HKY + I + G. Seven clusters belonging to Lentinus are represented in this phylogenetic reconstruction.
Phylogenetic analysis showed that the two culture sequences, EF 58a, and EF 58b, were arranged in a branch comprising another specimen of Lentinus crinitus (FTF200) with 0.99 BPP. In the phylogeny, it is also possible to observe that L. crinitus is polyphyletic, in accordance with previous works such as Grand (2004) and Seelan et al. (2015). Also, the literature indicates that this taxon presents a considerable morphological variation, which suggests that it is a complex of species, deserving a morphological review in order to define the lineage L. crinitus s.s. and perform taxonomical and nomenclatural treatment for those lineages previously named as L. crinitus s.l. also based on in-depth additional and more representative molecular analyses (Pegler 1983). In summary, molecular sequence-based identification and phylogenetic analysis of the strain allowed its definition as Lentinus, up to now belonging to L. crinitus s.l. Then, we choose to call this as L. crinitus EF 58 lineage. The species-complex Lentinus crinitus, as morphologically assumed, is common in different biomes or regions worldwide (Pegler 1983; Seelan et al. 2015; Drechsler-Santos et al. 2009, 2012).
Responses of L. crinitus EF 58 lineage in agar medium with 2,4-D
The same period of acclimatization to the culture medium with and without herbicide was observed (Table 3). The results of the factorial ANOVA and the Tukey’s multiple comparison test of the daily colony diameters for the treatments show that from the third day, there were no significant differences between the control and C1 treatments concerning the growth of L. crinitus.
Daily fungal growth rate to control and C1 treatment was 13.83 mm day−1. Similar values of growth rate (5, 8, 13, 15 and 18 mm day−1) were reported for Panus conchatus (Bull.) Fr., Lentinus conatus Berk., Lentinus sajor—caju (Fr.) Fr., Lentinus cladopus Lév. and Lentinus squarrosulus Mont., respectively, on solid medium—Potato Dextrose Agar (Sharma and Atri 2013). L. crinitus strains reached similar rates of mycelial extension rate (13.3–14.7 mm day−1) during growth on agar malt (2%) associated with Remazol Brilliant Blue R (RBBR) decolorization (Machado et al. 2005). Our data also agree with those reported by Magalhães et al. (2017), who observed the highest growth (18-mm day−1) for L. crinitus in PDA culture medium at 35 degrees and 5.0–5.5 of pH.
In fungi, pollutant dose-dependent growth has been described by Nicolas et al. (2016). They demonstrated that roundup herbicide (s. a. glyphosate) has an inhibitory effect on Aspergillus nidulans (Eidam) G at concentrations 100 times lower than recommended. Nevertheless, Kappas (1988) reported that this herbicide is 100 times less toxic than 2,4-D for the same fungus. In a study on the effect of pesticides in the growth of L. crinitus, Machado et al. (2006) reported that the fungus was inhibited by about 34% at the systemic fungicide benomyl concentration of 5 mg L−1, whereas that inhibition of about 66% and 92% was detected when 15 and 50 mg L−1 of the fungicide, respectively, were added to solid medium.
A short lag period of one day was observed by Vroumsia et al. (2005) for Aspergillus penicilloides Speg. and Umbelopsis isabellina (Oudem.) W. Gams, which exhibited 62% (1.40 mg removed) and 54% (1.20 mg removed), respectively, of 2,4-D depletion after 20 days of cultivation. The absence of lag phase in strains cultivated in culture medium with 2,4-D (Cycoń et al. 2011) or isolated from soil regularly treated with this herbicide (Silva et al. 2007) may indicate that the enzymes or enzyme systems involved in 2,4-D degradation by these strains were produced constitutively, and it is not necessary a prior acclimatization of the organisms to the compound. On the other hand, in bacteria, even though kinetic models have not been suggested, the production and accumulation of 2,4-DCP have an inhibitory effect by prolonging the lag phase and decreasing the rate of 2,4-D removal (Ning et al. 1997).
Tolerance and growth of WRF to xenobiotic compounds could change depending on their structure and concentration, in addition to the nutritional and the environmental characteristics (Magan et al. 2010). From the study on the effect of atrazine concentration on mycelial growth and the enzymatic activities of eight Basidiomycota (Cymatoderma elegans Jungh., Trametes elegans Spreng, Pycnoporus sanguineus (L.) Murrill strain 1, Pycnoporus sanguineus strain 2, Trametes maxima (Mont.) A. David and Rajchenb, Pleurotus sp. strain 1, Pleurotus sp. strain 2, Pleurotus djamor), Cupul et al. (2014) reported that in all strains the percentage inhibition of mycelial growth increased as the concentrations of the herbicide increased in the medium. Meanwhile, none of the eight strains of basidiomycetes tested were entirely inhibited by atrazine. Pleurotus sp. strain 1 showed the highest tolerance to the herbicide (EC50 of 2281.0 mg L−1 followed by Trametes maxima (CE50 of 1532.0 mg L−1) and P. sanguineus (CE50 of 1311.0 mg L−1). Pycnoporus sanguineus strain 1, Pleurotus sp. strain 2 and P. djamor were the most susceptible to the herbicide, with EC between 447.3 and 706.1 mg L−1 of atrazine. The tolerance of Diutina rugosa (H.W. Anderson) Khunnamw., Jindam., Limtong and Lachance, Lentinula edodes, Penicillium simplicissimum (Oudem.) Thom and Pleurotus ostreatus (Jacq.) P. Kumm to the atrazine herbicide at the final concentration of 10 mg L−1 was tested by Pereira (2011). The tolerant fungi were selected for atrazine degradation tests, and according to the authors, only P. ostreatus was able to degrade atrazine (71%), demonstrating that tolerance was not strictly related to degradation.
The production of enzymes responsible for cellulose and lignin degradation in a solid medium has been indicated through colorimetric assays for wild fungal species of Lentinus (Atri and Sharma 2011). Although the exposure doses do not result in any visual modification in fungi, metabolic effects can occur due to pesticide residues (Nicolas et al. 2016). In all our assays, the reaction of Bavendamm (gallic acid oxidation) was positive, evidenced by the formation of a dark brown halo around the colony, which indicates the degradation of gallic acid by oxidative enzymes. No significant differences in mycelial growth and halo size were observed considering the condition in which L. crinitus had been maintained before inoculation and cultivation in medium with gallic acid, i.e., with/without addition (treatment) of 2,4-D herbicide by 6, 10 and 15 days (exposition time). In all cases, the reaction halo of the oxidation of gallic acid has expanded over time (Table 4).
The spectrum of secreted proteins by L. crinitus comprise CAZymes (active carbohydrate enzymes), oxidase/reductases, proteases and lipase/esterases that provides a diverse enzymatic array with promising applications on several branches of industry (Cambri et al. 2016), and as well as the biomass yield, the secreted enzymes differed considerably among growing conditions (Kirsch et al. 2011, 2013).
As regards pollutant biodegradation, L. crinitus strains collected in a region contaminated with/without organochlorine industrial residuals exhibited laccase activity (4.3–5.8 U L−1), but they did not display MnP activity during RBBR decolorization (Machado et al. 2005). Moreira Neto et al. (2009) reported a maximum decolorization (100%) of RBBR by the enzymatic extract of L. crinitus with an initial pH between 2.5 and 3.5, concluding that the process is associated with the action of laccase-type oxidases (laccase activity of 28 and 35.0 U L−1, respectively, for each pH value). Niebisch et al. (2010) observed a decolorization of 95% for the textile dye reactive blue 220 (RB220) by L. crinitus that was related to biodegradation. They suggested the potential use for this organism in the remediation of real dye-containing effluents. Additionally, studies highlight the possible use of L. citrinus ligninolytic enzymes (de Araújo Conceição et al. 2017) and proteases (Machado et al. 2016) for application in agro-industrial waste treatment.
The presence of phenolic compounds, which act as laccase inducers, exhibit distinct effects depending on the fungus species or strain (Piscitelli et al. 2011). L. crinitus showed the highest RBBR decolorization (up to 98%) when grown in the presence of organochlorine compounds (Machado et al. 2005). Oxidation of organochlorine compounds has previously been associated with the increase in WRF’s laccase activity for PCP (Jeon et al. 2008), dimethylphenol (Piscitelli et al. 2011), atrazine (Pereira et al. 2013; Cupul et al. 2014) and diuron (Coelho-Moreira et al. 2018). The enzymatic diversity observed in L. crinitus revealed the capability to the breakdown and consumption of lignocellulose as well as the biotechnological potential of this fungus (Machado et al. 2005; Cambri et al. 2016). Despite some advances in the knowledge of optimal conditions to produce enzymes in L. crinitus, there is a lack of information regarding which enzymes are being stimulated or activated and their relation to organochlorine compounds degradation (Machado et al. 2005) and the effect of cultivation media on laccase production (Valle et al. 2014). On the other hand, Marim et al. (2018) reported maximum laccase activity (25.8–50 U mL−1) at pH between 6 and 7, temperature ranges from 28 to 37 °C and nitrogen concentrations higher than 2.8 g L−1 for two isolated of L. crinitus, concluding that laccase production is strain dependent for L. crinitus.
The morphological characteristics of L. crinitus after 6, 10 and 15 days of culture in control (without 2,4-D), C1 and C2 conditions were analyzed by optical microscopy of the aerial and submerged mycelium from the center and edges of the fungal colony. No significant morphological changes were observed in the mycelial samples from media added with the 2,4-D herbicide treatments (C1: 5.025 g L−1 of 2,4-D and C2: 50.25 g L−1 of 2,4-D) compared to the control treatment. The formation and pigmentation intensity (beige) of the mycelial, as well as the branching pattern of hyphae, were similar in all samples.
A lower proportion of structural (skeletal) hyphae was observed in comparison with the generative hyphae. The structuring hyphae had no coloration and were characterized as long (up to 1000 μm), thin (1–2.5 μm caliber), with no transverse septa and thicker wall. Thick-walled skeletal hyphae were found in all the five wild Lentinus species from northwest India (Sharma and Atri 2013).
For both C2 and C1 treatments, we observed generative hyphae with a contorted (twisted) lumen (Fig. 3a) that may represent a fungal response to explore, penetrate or grow in less hostile physicochemical regions. On the other hand, for C2, a shorter septation distance in generative hyphae, that is, more numerous septa, was observed approximately every 20 μm in the exposure time of 15 days.
Both types of hyphae had branched portions. Generative hyphae, with thin to slightly thick walls, were colored due to the cytoplasmic dye (Floxin 1%) used in the preparation of the slides and presented simple septation without clamp connections. Specific sites where the hyphae did not grow or the process of clamp formation did not occur (aborted branches) were observed (Fig. 3b). This morphological pattern of absence of the clamps was found at all treatments and exposition times, including in control. It would seem to be a condition of the cultivation itself, since it comes from the isolation from the basidioma. Although simple septation is not characteristic of the genus s.l. (Sharma and Atri 2013; Senthilarasu 2015), we observed this behavior to L. crinitus (EF58) in culture, and especially regarding this characteristic (loss of clamp connections) do not exist previous records for this species. This pattern in L. crinitus EF 58 strain would be associated with the fact of being an isolate of a basidioma collected in 1998 that was replicated several times in culture. The loss of clamp connections has been reported for other genera of Basidiomycetes as Armillaria (Fr.) Staude (Larsen et al. 1992), Lentinellus P. Karst. (Moreau et al. 2003), and Sparassis Fr. (Wang et al. 2004). One possible explanation about this condition is that the clamp connection formation is inhibited by the accumulation of secreted metabolites or an adverse pH shift (Larsen et al. 1992).
In all samples, the presence of chlamydospores (Fig. 3e)—asexual reproductive structures—spherical and cylindrical with equal proportions regarding the location of the same, intercalary, and terminal was detected. These asexual structures grow out on submerged or aerial hyphae (Põldmaa 2011) and serve as survival structures to overcome periods of unfavorable conditions (Son et al. 2012). It is suggested that both abiotic (temperature and growth media) and biotic (antagonistic microorganisms) determine the formation of chlamydospores (Goh et al. 2009). Areas with chlamydospore densification, especially in samples of mycelium from the edges of the culture plates, were observed (Fig. 3d). The shape and size of the chlamydospores (length: 7.0–22 μm and width: 3.0–9.0 μm) were similar in all treatments (Table 5).
The type and role of the factors that affect fungal morphology are not yet widely elucidated (Papagianni 2014). The branching density and network characteristics depend on the nutritional and environmental conditions (Islam et al. 2017). The abnormal growth of hyphae characterized by changes in morphology, such as the production of low-branching or unbranched long hyphae, is considered a strategy of fungi to deal with toxic conditions of the environment (Fomina et al. 2003), in which fungi grow by expanding toward less toxic sites and thus responding to environmental stress with minimal expenditure of resources (Ellegaard-Jensen et al. 2013). In this sense, studies on the effects of herbicides on specific microbial species are scarce (Nicolas et al. 2016). Among the results reported, besides growth retardation, glyphosate altered the mycelial organization in Aspergillus nidulans (Eidam) G. Winter (Nicolas et al. 2016), while the abnormal mycelial morphology in Arthrobotrys Corda fungal isolates caused by the herbicides paraquat, glyphosate, and oxyfluorfen was directly related to their concentration (Mensin et al. 2013). This type of alteration was not observed in the growth pattern of L. crinitus in treatments with the addition of 2,4-D at both levels (C1 and C2). In all cases, the mycelium was characterized by a relatively fast growth, with thin and frequently branching hyphae.
Also, the exposure time of L. crinitus to 2,4-D had a different effect for the caliber of generative fungal hyphae as well as the chlamydospore width and length in the treatments without and with 2,4-D addition (Fig. 4) for a total of n = 15 measures.
Typically, hyphae have diameters of 1–30 μm, depending on the species and growth environment (Islam et al. 2017). In this study, the caliber of hyphae ranged 2.5–3.5 μm, and the mean value after 6 days did not differ between the treatments compared (H = 0.87, p = 0.63) (Fig. 4a). After 10 days of contact with both herbicide solutions, C1 and C2, the diameters of these hyphae were significantly higher when compared to the control (H = 40.97, p < 0.001). However, as the exposure time to the herbicide increases, the mean hyphae size of treatment C1 was not significantly different for the value resulting from the control. As contact time increases, the fungus seemed to acclimatize itself to the culture medium, without presenting quantitative variations in the size of this variable. The average value of generative hyphae is significantly higher when compared to C1 and control (H = 12.31, p = 0.002) at the highest herbicide concentration (C2), even after 15 days (Fig. 4a).
In a study on diuron degradation potential, greater hyphae length was observed in five Morteriella sp. strains isolated from herbicide treatments (Ellegaard-Jensen et al. 2013). According to them, the toxicity of this herbicide or its metabolites in relation to Morteriella sp. strains cannot be excluded and co-metabolic degradation may represent a detoxification mechanism. When grown in medium containing penconazole, Aspergillus flavus Lynk. hyphae generated intermediate and terminal blisters and vesicle, while when grown in cypermethrin medium, their hyphae shrink, deformed and became swollen (Abboud 2014). On the other hand, the growth of the colony and its morphological characteristics (hyaline to pale brown hyphae, septate, branched and anastomosed) of diuron-degrading Neurospora intermedia F. L. Tai isolated on diuron-treated soil paired with N. intermedia without previous exposition to herbicide (Wang et al. 2017).
Regarding chlamydospore width, there were no significant differences in the mean value of this variable after 6, 10 and 15 days of in vitro cultivation of L. crinitus within each treatment, C1 and C2 (Fig. 4b). This means that exposure time would not affect this variable under the same culture conditions with the addition of the 2,4-D herbicide. After 6 days, the width of the chlamydospores corresponding to the C2 treatment was smaller compared to the other treatments (H = 6.44, p = 0.0330). However, after 10 and 15 days, the mean value for this variable was not different between the treatments studied (H = 2.44, p = 0.2708 and H = 1.67, p = 0.4033) (Fig. 4b). Regarding chlamydospore length (Fig. 4c), in each treatment, there were no significant differences during the exposure to 2,4-D (H = 3.43, p = 0.1778 for 6 days, H = 5.58, p = 0.0599 for 10 days and H = 1.83, p = 0.3949 for 15 days). When comparing the different treatments for 6 days, no significant differences were observed between the average values of chlamydospore length (H = 0.31, p = 0.8568). Already for 10 days, the values follow an increasing order: C2 > C1 > Control (H = 17.22, p = 0.0002). After 15 days of exposure, the average values of chlamydospore length for C1 and C2 were higher than the value of the control treatment (H = 6.80, p = 0.0315). Previous studies with fungi showed different results on the effect of pesticides on the morphological characteristics of the studied microorganisms. Abboud (2014) reported that A. flavus failed to form reproduction structures (conidiophores) and sporulate when growing in penconazole medium, while the diameter of conidiophores decreased in size with cypermethrin. On the other hand, it has been reported that N. intermedia strains could degrade organochlorine compounds without changing their internal mycelial structure (Wang et al. 2017). According to the authors, N. intermedia conidiophores isolated from diuron-treated soil did not differ with the shape and size characteristics of N. intermedia cultivated without previous exposition to the herbicide. In addition to the structure sizes, the shape of chlamydospores was described. When considered the length/width ratio (Q) in each condition, the predominant morphology of chlamydospores was subcylindrical (Table 5).
The bacilliform—filiform category in the C2 treatment (submersed—center) corresponded to the contribution of one (of n = 15) measure (22 × 6 µm). The production of chlamydospores predominantly subcylindrical, in nature as well as in culture, has been described for the Ascomycota Cladobotryum sp. and Hypomyces sp. (Põldmaa 2011). On the other hand, the quotient Q for basidiospores has also been used for micro-morphological characterization of the Basidiomycota Deconica sp. (Q = 1.2–1.6), Mycena sp. (Q = 1.4–1.8), Phaeomarasmius sp. (Q = 1.8–2.3), Phlebia sp. (Q = 2.1–2.4), Pluteus sp. (Q = 1.1–1.3), Postia sp. (Q = 2.6–3.1), Resinicium sp. (Q = 2.0–3.0), Scytinostroma sp. (Q = 1.0), Tricholomopsis sp. (Q = 1.5–1.8), and Tyromyces sp. (Q = 1.5–2.0) (Park et al. 2017).
Despite representing a basis for exploiting fungi for application in environmental cleanup or bioremediation (Carascal et al. 2017), the biological tolerance to a specific chemical pollutant not necessarily is associated with the possibility of performing metabolic detoxification of the compound (Pereira 2011). In a study over the ability of WRF to remove pentachlorophenol (PCP), Chiu et al. (1998) showed that tolerance level of certain fungi toward PCP did not correlate with its degradative capacity. Although Armillaria mellea (Vahl) P. Kumm. was characterized as slow growers due to taking 36–54 days to cover a 9-cm plate fully, this strain showed a great capacity for PCP degradation. Meanwhile, Polyporus sp. was considered a fast grower (4–10 days) that showed a great ability for biosorption.
As regards 2,4-D, tolerance and degradation capabilities have been described for many species of basidiomycetes as L. edodes (Tsujiyama et al. 2013), Phanerodontia chrysosporium (Burds.) Hjortstam and Ryvarden (Valli and Gold 1991; Donnelly et al. 1993; Yadav and Reddy 1993), Gautieria crispa E. L. Stewart and Trappe, Gautieria otthii Trog, Schenella simplex T. Macbr., Rhizopogon vinicolor A. H. Sm., Sclerogaster pacificus Zeller and C. W. Dodge, Trappea darkeri (Zeller) Castellano (Donnelly et al. 1993), Dichomitus squalens (P. Karst.) D. A. Reid (Reddy et al. 1997), and Trametes versicolor (L.) Lloyd (Hernández Mendieta et al. 2013).
Herbicide tolerance is generally regarded as the absence of general toxic effects at the macroscopic level, ignoring potential cellular effects if they do not result into visible consequences (growth, morphology, yield) (Nicolas et al. 2016). Analysis of the ultrastructure in PCP-tolerant fungi showed that at concentrations of 100 mg L−1 this compound produced the collapse of fungal structures, hyphae and spores, in Trichoderma Pers. and Cunninghamella Matr. strains (Sing et al. 2014). Despite these morphological alterations, Cunninghamella sp. UMAS SD12 has shown the highest growth rate and tolerance to PCP and removed up to 51.7% of this organochlorine after 15 days. The fact that an organism tolerates or degrades an organochlorinated compound does not mean that it does not suffer morphological or physiological alterations due to exposure to it. A recent study has postulated that pesticides can affect the resistance of a human pathogen fungus (genus Cryptococcus) by altering the fungal morphology and causing tolerance to the clinical drug fluconazole (Bastos et al. 2018).
Conclusion
The agar-plate culture system was efficient in evaluating the tolerance of fungi to the herbicide 2,4-D. To the best of our knowledge, this is the first study that has demonstrated the potential of L. crinitus in tolerate this pesticide in a wide range (5.025–670 g L−1) when added in medium with agar what represents the starting point of bioremediation process with practical applications.
Previous work on organochlorine removal by fungi focused primarily on its potential as a degradation agent. In contrast, less is known about the morphological and physiological effect of these chemical compounds on the ultrastructure of microorganisms.
We did not find significant morphological alterations of the fungal structure sizes (hyphae and chlamydospores) during the experiment—the similar morphological responses of L. crinitus after cultivation with or without 2,4-D, suggesting that there was not deleterious effect on the ultrastructure of this fungi due to the presence of 2,4-D in the culture medium. The absence of clamps in L. crinitus culture is not a consequence of 2,4-D exposition, and this characteristic was also observed in control assays. To the best of our knowledge, this is the first record of loss of clamp connections for Lentinus species in cultures. Few studies investigate the mycelium characteristics after herbicide exposition regarding reproductive structures, hyphae feature and exposition time–structure property relationships, which are relevant to a variety of applications of mycelium as is the case of a bioreactor for the treatment of contaminated effluents.
References
Abboud MAA (2014) Bioimpact of application of pesticides with plant growth hormone (gibberellic acid) on target and non-target microorganisms. J Saudi Chem Soc 18:1005–1010. https://doi.org/10.1016/j.jscs.2011.12.004
Adebayo OS, Kabbashi NA, Alam MZ, Mirghani MS (2015) Recycling of organic wastes using locally isolated lignocellulolytic strains and sustainable technology. J Mater Cycles Waste Manag 17:769–780. https://doi.org/10.1007/s10163-014-0309-z
Adenipekun CO, Ogunjobi AA, Ogunseye OA (2011) Management of polluted soils by a white-rot fungus: Pleurotus pulmonarius. AU J Technol 15:57–61
Ahlborg UG, Thunberg TM (1980) Chlorinated phenols: occurrence, toxicity, metabolism, and environmental impact. Crit Rev Toxicol 7:1–35. https://doi.org/10.3109/10408448009017934
Al-Ghamdi AY (2016) Degradation of some textile industry effluent dyes by Ganoderma applanatum. Int J Biol Sci 9:144–147. https://doi.org/10.12692/ijb/9.5.144-147
Atri N, Sharma SK (2011) Qualitative estimation of cellulases and lignin modifying enzymes in five wild Lentinus species selected from North West India. Acad J Plant Sci (AJPS) 4:105–109. https://doi.org/10.5829/idosi.ajps.2012.5.1.235
Attarat J, Phermthai T (2014) Bioactive compounds in three edible Lentinus mushrooms. Walailak J Sci Technol (WJST) 12:491–504. https://doi.org/10.2004/wjst.v12i2.842
Barbieri A, Quagliariello V, Del Vecchio V, Falco M, Luciano A, Amruthraj NJ, Nasti G, Ottaiano A, Berretta M, Iaffaioli RV, Arra C (2017) Anticancer and anti-inflammatory properties of Ganoderma lucidum extract effects on melanoma and triple-negative breast cancer treatment. Nutrients 9:1–9. https://doi.org/10.3390/nu9030210
Bastos RW, Carneiro HCS, Oliveira LVN, Rocha KM, Freitas GJC, Costa MC, Magalhães TFF, Carvalho VSD, Rocha CE, Ferreira GF, Paixão TA, Moyrand F, Janbon G, Santos DA (2018) Environmental triazole induces cross-resistance to clinical drugs and affects morphophysiology and virulence of Cryptococcus gattii and C. neoformans. Antimicrob Agents Chemother 62:e01179-01117. https://doi.org/10.1128/AAC.01179-17
Baumgartner D, Souza EG, Coelho SRM, Maggi MF (2017) Correlation between 2,4-D herbicide residues and soil attributes in southern of Brazil. Rev Ciênc Agron 48:428–437. https://doi.org/10.5935/1806-6690.20170050
Bayramoglu G, Denizli A, Bektas S, Yakup Arica M (2002) Entrapment of Lentinus sajor-caju into Ca-alginate gel beads for removal of Cd(II) ions from aqueous solution: preparation and biosorption kinetics analysis. Microchem J 72:63–76. https://doi.org/10.1016/S0026-265X(01)00151-5
Boh B, Berovic M, Zhang J, Zhi-Bin L (2007) Ganoderma lucidum and its pharmaceutically active compounds. Biotechnol Annu Rev 13:265–301. https://doi.org/10.1016/S1387-2656(07)13010-6
Brazil, Ministry of Health (2011) Ordinance 2914 of December 12, 2011. (in Portuguese). http://bvsms.saude.gov.br/bvs/saudelegis/gm/2011/prt2914_12_12_2011.html. Accessed 30 Sept 2019
Budzinski H, Couderchet M (2018) Environmental and human health issues related to pesticides: from usage and environmental fate to impact. Environ Sci Pollut R 25:14277–14279. https://doi.org/10.1007/s11356-018-1738-3
Bukowska B (2003) Effects of 2,4-D and its metabolite 2,4-dichlorophenol on antioxidant enzymes and level of glutathione in human erythrocytes. Comp Biochem Physiol C Toxicol Pharmacol 135:435–441. https://doi.org/10.1016/s1532-0456(03)00151-0
Cambri G, de Sousa MM, Fonseca DM, Marchini F, da Silveira JL, Paba J (2016) Analysis of the biotechnological potential of a Lentinus crinitus isolate in the light of its secretome. J Proteome Res 15:4557–4568. https://doi.org/10.1021/acs.jproteome.6b00636
Carascal M, del Rosario M, Notarte KI, Huyop F, Yaguchi T, Dela Cruz TE (2017) Butachlor biodegradation potential of fungi isolated from submerged wood and surface water collected in Taal Lake, Philippines. Philipp Sci Lett 10:81–88
Chen Y, Lan P (2018) Total syntheses and biological evaluation of the Ganoderma lucidum alkaloids lucidimines B and C. ACS Omega 3:3471–3481. https://doi.org/10.1021/acsomega.8b00295
Chen G-Q, Zeng G-M, Tu X, Niu C-G, Huang G-H, Jiang W (2006) Application of a by-product of Lentinus edodes to the bioremediation of chromate contaminated water. J Hazard Mate 135:249–255. https://doi.org/10.1016/j.jhazmat.2005.11.060
Chicatto JA, Rainert KT, Gonçalves MJ, Helm CV, Altmajer-Vaz D, Tavares LBB (2018) Decolorization of textile industry wastewater in solid state fermentation with Peach-Palm (Bactris gasipaes) residue. Braz J Biol 78:718–727. https://doi.org/10.1590/1519-6984.175074
Chiu SW, Ching ML, Fong KL, Moore D (1998) Spent oyster mushroom substrate performs better than many mushroom mycelia in removing the biocide pentachlorophenol. Mycol Res 102:1553–1562. https://doi.org/10.1017/S0953756298007588
Ćilerdžić J, Stajić M, Vukojević J (2016) Degradation of wheat straw and oak sawdust by Ganoderma applanatum. Int Biodeterior Biodegrad 114:39–44. https://doi.org/10.1016/j.ibiod.2016.05.024
Ćilerdžić J, Galić M, Vukojević J, Brčeski I, Stajić M (2017) Potential of selected fungal species to degrade wheat straw, the most abundant plant raw material in Europe. BMC Plant Biol 17:249. https://doi.org/10.1186/s12870-017-1196-y
Coelho-Moreira JS, Brugnari T, Sá-Nakanishi AB, Castoldi R, de Souza CGM, Bracht A, Peralta RM (2018) Evaluation of diuron tolerance and biotransformation by the white-rot fungus Ganoderma lucidum. Fungal Biol 122:471–478. https://doi.org/10.1016/j.funbio.2017.10.008
Cupul WC, Abarca GH, Vázquez RR, Salmones D, Hernández RG, Gutiérrez EA (2014) Response of ligninolytic macrofungi to the herbicide atrazine: dose-response bioassays. Rev Argent Microbiol 46:348–357. https://doi.org/10.1016/S0325-7541(14)70094-X
Cycoń M, Żmijowska A, Piotrowska-Seget Z (2011) Biodegradation kinetics of 2,4-D by bacterial strains isolated from soil. Cent Eur J Biol 6:188–198. https://doi.org/10.2478/s11535-011-0005-0
Da Silva Coelho J, Oliveira AL, Souza CGM, Bracht A, Peralta R (2010) Effect of the herbicides bentazon and diuron on the production of ligninolytic enzymes by Ganoderma lucidum. Int Biodeterior Biodegrad 64:156–161. https://doi.org/10.1016/j.ibiod.2009.12.006
Dakhakhni TH, Raouf GA, Qusti SY (2016) Evaluation of the toxic effect of the herbicide 2, 4-D on rat hepatocytes: an FT-IR spectroscopic study. Eur Biophys J 45:311–320. https://doi.org/10.1007/s00249-015-1097-7
Davidson WR, Campbell WA, Baisdell DJ (1938) Differentiations of wood-decaying fungi by their reactions on gallic or tannic acid medium. J Agric Res 67:683–695
de Araújo Conceição T, Koblitz M, Kamida H, Góes-Neto A (2017) Study of the production of Lentinus crinitus (L.) Fr. lignolytic enzymes grown on agro-industrial waste. Adv Biosci Biotechnol 8:259–272. https://doi.org/10.4236/abb.2017.88019
Dentinger BTM, Margaritescu S, Moncalvo JM (2010) Rapid and reliable high-throughput methods of DNA extraction for use in barcoding and molecular systematics of mushrooms. Mol Ecol Resour 10:628–633. https://doi.org/10.1111/j.1755-0998.2009.02825.x
Ditzelmüller G, Loidl M, Streichsbier F (1989) Isolation and characterization of a 2,4-dichlorophenoxyacetic acid-degrading soil bacterium. Appl Microbiol Biotechnol 31:93–96. https://doi.org/10.1007/bf00252535
Donnelly PK, Entry JA, Crawford DL (1993) Degradation of atrazine and 2,4-dichlorophenoxyacetic acid by mycorrhizal fungi at three nitrogen concentrations in vitro. Appl Environ Microbiol 59:2642–2647
dos Santos Bazanella GC, de Souza DF, Castoldi R, Oliveira RF, Bracht A, Peralta RM (2013) Production of laccase and manganese peroxidase by Pleurotus pulmonarius in solid-state cultures and application in dye decolorization. Folia Microbiol 58:641–647. https://doi.org/10.1007/s12223-013-0253-7
Drechsler-Santos ER, Gibertoni TB, Góes-Neto A, Cavalcanti MAQ (2009) A re-evaluation of the lignocellulolytic Agaricomycetes from the Brazilian semi-arid region. Mycotaxon 108:241–244. https://doi.org/10.5248/108.241
Drechsler-Santos ER, Wartchow F, Coimbra V, Gibertoni T, Cavalcanti MAQ (2012) Studies on lentinoid fungi (Lentinus and Panus) from the semiarid region of Brazil. J Torrey Bot Soc 139:437–446. https://doi.org/10.3159/TORREY-D-12-00019.1
Duarte KR, Justino C, Panteleitchouk T, Zrineh A, Freitas AC, Duarte AC, Rocha-Santos TAP (2014) Removal of phenolic compounds in olive mill wastewater by silica–alginate–fungi biocomposites. Int J Environ Sci Technol 11:589–596. https://doi.org/10.1007/s13762-013-0268-2
Dulay RMR, Flores KS, Reyna CT, Marquez DHH, De la Cruz AG, Sofronio PK, Reyes RG (2015) Mycelial biomass production and antioxidant activity of Lentinus tigrinus and Lentinus sajor-caju in indigenous liquid culture. Mycosphere 6:659–666. https://doi.org/10.5943/mycosphere/6/6/2
EC, European Commission (1998) Council Directive 98/83/EC of 3 November 1998 on the quality of water intended for human consumption. Off J Eur Commun 330:332
Ellegaard-Jensen L, Aamand J, Kragelund BB, Johnsen AH, Rosendahl S (2013) Strains of the soil fungus Mortierella show different degradation potentials for the phenylurea herbicide diuron. Biodegradation 24:765–774. https://doi.org/10.1007/s10532-013-9624-7
Erguven GO (2018) Comparison of some soil fungi in bioremediation of herbicide acetochlor under agitated culture media. Bull Environ Contam Toxicol 100:570–575. https://doi.org/10.1007/s00128-018-2280-1
Erguven G, Demir G (2019) Evaluation of the detoxification potential of micrococcus strains and plants for bioremediate organochlorine herbicides. IJIAAR 3:353–364. https://doi.org/10.29329/ijiaar.2019.206.1
Erguven G, Koçak E (2019) Determining the detoxification potential of some soil bacteria and plants on bioremediation of deltamethrin, fenvalerate and permethrin pesticides. EJAR 3:36–47
Erguven GO, Yildirim N (2019) The evaluation of imidacloprid remediation in soil media by two bacterial strains. Curr Microbiol 76:1461–1466. https://doi.org/10.1007/s00284-019-01774-w
FAO, Food and Agriculture Organization of the United Nations (2018) More people, more food, worse water? A global review of water pollution from agriculture. FAO, Rome, 207 pp. http://www.fao.org/3/ca0146en/CA0146EN.pdf. Accessed 29 Jan 2020
Ferreira-Guedes S, Mendes B, Leitão AL (2012) Degradation of 2,4-dichlorophenoxyacetic acid by a halotolerant strain of Penicillium chrysogenum: antibiotic production. Environ Technol 33:677–686. https://doi.org/10.1080/09593330.2011.588251
Fomina M, Ritz K, Gadd GM (2003) Nutritional influence on the ability of fungal mycelia to penetrate toxic metal-containing domains. Mycol Res 107:861–871. https://doi.org/10.1017/S095375620300786X
Fournier JC, Catroux G (1980) L’utilisation de souches de micro-organismes de collection pour l’etude de la biodegradabilite des pesticides. Chemosphere 9:33–38. https://doi.org/10.1016/0045-6535(80)90152-6
Gaitan IJ, Medina SC, González JC, Rodríguez A, Espejo AJ, Osma JF, Sarria V, Alméciga-Díaz CJ, Sánchez OF (2011) Evaluation of toxicity and degradation of a chlorophenol mixture by the laccase produced by Trametes pubescens. Bioresour Technol 102:3632–3635. https://doi.org/10.1016/j.biortech.2010.11.040
Gąsecka M, Drzewiecka K, Siwulski M, Sobieralski K (2015) Evaluation of polychlorinated biphenyl degradation through refuse from Pleurotus ostreatus, Lentinula edodes and Agaricus bisporus production. Folia Hortic 27:135–144. https://doi.org/10.1515/fhort-2015-0023
Ghobadi R, Mohammadi R, Chabavizade J, Sami M (2018) Effect of Ganoderma lucidum powder on oxidative stability, microbial and sensory properties of emulsion type sausage. Adv Biomed Res 7:24. https://doi.org/10.4103/2277-9175.225595
Gianfreda L, Rao MA (2004) Potential of extra cellular enzymes in remediation of polluted soils: a review. Enzyme Microb Technol 35:339–354. https://doi.org/10.1016/j.enzmictec.2004.05.006
Góes-Neto A, Loguercio-Leite C, Trinidad Guerrero R (2005) DNA extraction from frozen field-collected and dehydrated herbarium fungal basidiomata: performance of SDS and CTAB-based methods. Biotemas 18:19–32. https://doi.org/10.5007/%25x
Goh YK, Daida P, Vujanovic V (2009) Effects of abiotic factors and biocontrol agents on chlamydospore formation in Fusarium graminearum and Fusarium sporotrichioides. Biocontrol Sci Technol 19:151–167. https://doi.org/10.1080/09583150802627033
Gomes E, Aguiar AP, Carvalho CC, Bonfá MRB, Silva R, Boscolo M (2009) Ligninases production by Basidiomycetes strains on lignocellulosic agricultural residues and their application in the decolorization of synthetic dyes. Braz J Microbiol 40:31–39. https://doi.org/10.1590/S1517-83822009000100005
Grand EA (2004) Systematics and species concepts in the genera Lentinus Fr. and Panus Fr., with emphasis on the Lentinus tigrinus, L. crinitus and Panus lecomtei complexes. Univ. Tennessee Press, Knoxville. Doctoral dissertation. University of Tennessee, Knoxville. 116 p
Henriques GS, Simeone MLF, Amazonas MALA (2008) In vivo protein quality evaluation of champignon of Brazil (Agaricus brasiliensis Wasser et al.). Braz J Nutr 21:535–543. https://doi.org/10.1590/S1415-52732008000500006(in Portuguese)
Henriques GS, Helm CV, Busato AP, Simeone MLF (2016) Lipid profile and glycemic response of rats fed on a semi-purified diet supplemented with Agaricus brasiliensis mushroom. Acta Sci Health Sci 38:71–79. https://doi.org/10.4025/actascihealthsci.v38i1.29185
Hernández Mendieta E, Guillén Sánchez D, López Martínez V, Tejacal IA, Andrade Rodríguez M, Villegas Torres OG, Martínez Fernández E, Huerta Lara M, Segura Miranda A (2013) Identificación del agente causal de la pudrición blanca en Morelos, México. Rev Colomb Biotechnol 15:1–8. https://doi.org/10.15446/rev.colomb.biote.v15n2.41744
Hiran S, Kumar S (2017) 2,4-D Dichlorophenoxyacetic acid poisoning; case report and literature review. Asia Pac J Med Toxicol 6:29–33. https://doi.org/10.22038/apjmt.2017.8475
Hood IA, Beets PN, Gardner JF, Kimberley MO, Power MWP, Ramsfield TD (2008) Basidiomycete decay fungi within stems of Nothofagus windfalls in a Southern Hemisphere beech forest. Can J Forest Res 38:1897–1910. https://doi.org/10.1139/X08-041
Huang GJ, Yang CM, Chang YS, Amagaya S, Wang HC, Hou WC, Huang SS, Hu ML (2010) Hispolon suppresses SK-Hep1 human hepatoma cell metastasis by inhibiting matrix metalloproteinase-2/9 and urokinase-plasminogen activator through the PI3K/Akt and ERK signaling pathways. J Agric Food Chem 58:9468–9475. https://doi.org/10.1021/jf101508r
Huang HY, Chieh SY, Tso TK, Chien TY, Lin HT, Tsai YC (2011) Orally administered mycelial culture of Phellinus linteus exhibits antitumor effects in hepatoma cell-bearing mice. J Ethnopharmacol 133:460–466. https://doi.org/10.1016/j.jep.2010.10.015
Islam MR, Tudryn G, Bucinell R, Schadler L, Picu RC (2017) Morphology and mechanics of fungal mycelium. Sci Rep 7:13070. https://doi.org/10.1038/s41598-017-13295-2
Islam F, Wang J, Farooq MA, Khan MSS, Xu L, Zhu J, Zhao M, Munos S, Li QX, Zhou W (2018) Potential impact of the herbicide 2,4-dichlorophenoxyacetic acid on human and ecosystems. Environ Int 111:332–351. https://doi.org/10.1016/j.envint.2017.10.020
Itoh K, Kinoshita M, Morishita S, Chida M, Suyama K (2013) Characterization of 2,4-dichlorophenoxyacetic acid and 2,4,5-trichlorophenoxyacetic acid-degrading fungi in Vietnamese soils. FEMS Microbiol Ecol 84:124–132. https://doi.org/10.1111/1574-6941.12043
Jarosz-Wilkołazka A, Kochmańska-Rdest J, Malarcz̄yk E, Wardas W, Leonowicz A (2002) Fungi and their ability to decolourize azo and anthraquinonic dyes. Enzyme Microb Technol 30:566–572. https://doi.org/10.1016/S0141-0229(02)00022-4
Jeon JR, Murugesan K, Kim YM, Kim EJ, Chang YS (2008) Synergistic effect of laccase mediators on pentachlorophenol removal by Ganoderma lucidum laccase. Appl Microbiol Biotechnol 81:783–790. https://doi.org/10.1007/s00253-008-1753-2
Jin X, Yu X, Zhu G, Zheng Z, Feng F, Zhang Z (2016) Conditions optimizing and application of laccase-mediator system (LMS) for the laccase-catalyzed pesticide degradation. Sci Rep 6:35787. https://doi.org/10.1038/srep35787
Justo A, Miettinen O, Floudas D, Ortiz-Santana B, Sjokvist E, Lindner D, Nakasone K, Niemela T, Larsson KH, Ryvarden L, Hibbett DS (2017) A revised family-level classification of the Polyporales (Basidiomycota). Fungal Biol 121:798–824. https://doi.org/10.1016/j.funbio.2017.05.010
Kabbashi N, Suraj O, Alam MZ, Elwathig MSM (2014) Kinetic study for compost production by isolated fungal strains. Int J Waste Resour 4:169. https://doi.org/10.4172/2252-5211.1000169
Kalmiş E, Azbar N, Kalyoncu F (2007) Agar-Plate screening for textile dye decolorisation by white rot fungi Pleurotus species; Pleurotus cornucopiae var citrinopileatus, P. djamor, P. eryngii, P. ostreatus and P. sajor-caju. Fresenius Environ Bull 16:1309–1314
Kappas A (1988) On the mutagenic and recombinogenic activity of certain herbicides in Salmonella typhimurium and in Aspergillus nidulans. Mutation Res 204:615–621
Katoh K, Standley DM (2013) MAFFT multiple sequence alignment software version 7: improvements in performance and usability. Mol Biol Evol 30:772–780. https://doi.org/10.1093/molbev/mst010
Kaur H, Kapoor S, Kaur G (2016) Application of ligninolytic potentials of a white-rot fungus Ganoderma lucidum for degradation of lindane. Environ Monit Assess 188:588. https://doi.org/10.1007/s10661-016-5606-7
Kearse M, Moir R, Wilson A, Stones-Havas S, Cheung M, Sturrock S, Buxton S, Cooper A, Markowitz S, Duran C, Thierer T, Ashton B, Meintjes P, Drummond A (2012) Geneious Basic: an integrated and extendable desktop software platform for the organization and analysis of sequence data. Bioinformatics 28:1647–1649. https://doi.org/10.1093/bioinformatics/bts199
Kirsch LS, Pinto AC, Porto TS, Porto AL, Teixeira MF (2011) The influence of different submerged cultivation conditions on mycelial biomass and protease production by Lentinus citrinus Walleyn et Rammeloo DPUA 1535 (Agaricomycetideae). Int J Med Mushrooms 13:185–192. https://doi.org/10.1615/IntJMedMushr.v13.i2.110
Kirsch LS, Ebinuma V, Teixeira MFS (2013) Mycelial biomass and biochemical properties of proteases produced by Lentinus citrinus DPUA 1535 (Higher Basidiomycetes) in submerged cultivation. Int J Med Mushrooms 15:505–515. https://doi.org/10.1615/IntJMedMushr.v15.i5.80
Kozarski M, Klaus A, Niksic M, Jakovljevic D, Helsper JPFG, Van Griensven LJLD (2011) Antioxidative and immunomodulating activities of polysaccharide extracts of the medicinal mushrooms Agaricus bisporus, Agaricus brasiliensis, Ganoderma lucidum and Phellinus linteus. Food Chem 129:1667–1675. https://doi.org/10.1016/j.foodchem.2011.06.029
Kuhar F, Furci G, Drechsler-Santos ER, Pfister DH (2018) Delimitation of Funga as a valid term for the diversity of fungal communities: the fauna, flora & funga proposal (FF&F). Mycolens, IMA Fungus 9:71–74. https://doi.org/10.1007/BF03449441
Kumar S, Stecher G, Tamura K (2016) MEGA7: molecular evolutionary genetics analysis version 7.0 for bigger datasets. Mol Biol Evol 33:1870–1874. https://doi.org/10.1093/molbev/msw054
Larsen MJ, Banik MT, Burdsall HH (1992) Clamp connections in North American Armillaria species: occurrence and potential application for delimiting species. Mycologia 84:214–218. https://doi.org/10.2307/3760253
Lurquin PF (2016) Production of a toxic metabolite in 2,4-D-resistant GM crop plants. 3 Biotech 6:82. https://doi.org/10.1007/s13205-016-0387-9
Machado KMG, Matheus DR, Bononi VLR (2005) Ligninolytic enzymes production and Remazol brilliant blue R decolorization by tropical Brazilian basidiomycetes fungi. Braz J Microbiol 36:246–252. https://doi.org/10.1590/S1517-83822005000300008
Machado KMG, Matheus DR, Rodrigues TA, Bononi VLR (2006) Enhancement of growth of Lentinus crinitus in soil using benomyl and vegetable oil. Braz J Microbiol 37:425–427. https://doi.org/10.1590/S1517-83822006000400004
Machado ARG, Teixeira MFS, Souza Kirsch L, Campelo MCL, Aguiar Oliveira IM (2016) Nutritional value and proteases of Lentinus citrinus produced by solid state fermentation of lignocellulosic waste from tropical region. Saudi J Biol Sci 23:621–627. https://doi.org/10.1016/j.sjbs.2015.07.002
Magalhães AAS, Carvalho TB, Souza AQL, Pereira JO (2017) Efeito da temperatura e do pH no crescimento micelial do fungo amazônico Lentinus crinitus (L.). In: Oliveira LA, Bentes JLS, Jesus MA, Rocha LC, Fernandes OC, Andrade SL, Souza AQL (eds) Diversidade Microbiana da Amazônia. Editora INPA, Manaus, pp 200–207
Magan N, Fragoeiro S, Bastos C (2010) Environmental factors and bioremediation of xenobiotics using white rot fungi. Mycobiology 38:238–248. https://doi.org/10.4489/MYCO.2010.38.4.238
Mahmood I, Imadi SR, Shazadi K, Gul A, Hakeem KR (2016) Effects of pesticides on environment. In: Hakeem KR, Akhtar MS, Abdullah SNA (eds) Plant soil and microbes: volume 1—implications in crop science. Springer, Cham, pp 253–269. https://doi.org/10.1007/978-3-319-27455-3_13
Manzano-León AM, Ramos-Leal M, Domínguez-Guilarte O, Sánchez López MI, Chinea-Borrell R, Batista-Utria A, Cabarroi-Hernández M, Jiménez Romero L, Alfonso-González M, Guerra-Rivera G (2011) Isolation and selection of white-rot fungi for decolourisation of industrial dyes. Rev CENIC Cienc Biol 42:17–23
Marim RA, Avelino KV, Linde GA, Colauto NB, Valle JS (2018) Lentinus crinitus strains respond differently to cultivation pH and temperature. Genet Mol Res 17:gmr16039885. https://doi.org/10.4238/gmr16039885
Masaphy S, Levanon D, Vaya J, Henis Y (1993) Isolation and characterization of a novel atrazine metabolite produced by the fungus Pleurotus pulmonarius, 2-Chloro-4-Ethylamino-6-(1-Hydroxyisopropyl) Amino-1,3,5-Triazine. Appl Environ Microbiol 59:4342–4346. https://doi.org/10.1128/AEM.59.12.4342-4346.1993
Mayorga R, Sanchez JE, Gutierrez RF, Calixto-Romo MA (2017) Degradation of sodium metamizole by enzymatic extracts from some white rot fungi. Sydowia 69:205–214. https://doi.org/10.12905/0380.sydowia69-2017-0205
Mensin S, Soytong K, McGovern R, To-anun C (2013) Effect of agricultural pesticides on the growth and sporulation of nematophagous fungi. J Agric Technol 9:953–961
Miller MA, Pfeiffer W, Schwartz T (2010) Creating the CIPRES science gateway for inference of large phylogenetic trees. In: 2010 gateway computing environments workshop (GCE), pp. 1-8. http://doi.org/10.1109/GCE.2010.5676129
Miyashira CH, Tanigushi DG, Gugliotta AM, Santos DYAC (2010) Comparison of radial growth rate of the mutualistic fungus of Atta sexdens rubropilosa forel in two culture media. Braz J Microbiol 41:506–511. https://doi.org/10.1590/S1517-83822010000200035
Money NP (2016) Fungal diversity. In: Watkinson SC, Boddy L, Money NP (eds) The fungi. Academic Press, Boston, pp 1–36. https://doi.org/10.1016/B978-0-12-382034-1.00001-3
Moreau PA, Garcia G, Roux P (2003) Lentinellus herbarum, a rediscovered unclamped species. Mycol Res 107:757–762. https://doi.org/10.1017/S0953756203007858
Moreira Neto SL, Matheus DR, Machado KMG (2009) Influence of pH on the growth, laccase activity and RBBR decolorization by tropical basidiomycetes. Braz Arch Biol Technol 52:1075–1082. https://doi.org/10.1590/S1516-89132009000500003
Nicolas V, Oestreicher N, Velot C (2016) Multiple effects of a commercial Roundup(R) formulation on the soil filamentous fungus Aspergillus nidulans at low doses: evidence of an unexpected impact on energetic metabolism. Environ Sci Pollut Res Int 23:14393–14404. https://doi.org/10.1007/s11356-016-6596-2
Niebisch CH, Malinowski AK, Schadeck R, Mitchell DA, Kava-Cordeiro V, Paba J (2010) Decolorization and biodegradation of reactive blue 220 textile dye by Lentinus crinitus extracellular extract. J Hazard Mater 180:316–322. https://doi.org/10.1016/j.jhazmat.2010.04.033
Ning Z, Kennedy KJ, Fernandes L (1997) Anaerobic degradation kinetics of 2,4-dichlorophenol (2,4-DCP) with linear sorption. Water Sci Technol 35:67–75. https://doi.org/10.1016/S0273-1223(96)00916-X
Nitayapat N, Prakarnsombut N, Lee SJ, Boonsupthip W (2015) Bioconversion of tangerine residues by solid-state fermentation with Lentinus polychrous and drying the final products. LWT Food Sci Technol 63:773–779. https://doi.org/10.1016/j.lwt.2015.03.016
Okeke BC, Smith JE, Paterson A, Watson-Craik IA (1993) Aerobic metabolism of pentachlorophenol by spent sawdust culture of “Shiitake” mushroom (Lentinus edodes) in soil. Biotechnol Lett 15:1077–1080. https://doi.org/10.1007/BF00129941
Papagianni M (2014) Characterization of fungal morphology using digital image analysis techniques. J Microb Biochem Technol 6:189–194. https://doi.org/10.4172/1948-5948.1000142
Park MS, Cho HJ, Kim NK, Park JY, Lee H, Park KH, Kim M-J, Kim J-J, Kim C, Lim YW (2017) Ten new recorded species of macrofungi on Ulleung Island, Korea. Mycobiology 45:286–296. https://doi.org/10.5941/MYCO.2017.45.4.286
Pegler DN (1983) The genus Lentinus: A world monograph. Kew Bull. Add. Ser. H. M. S. O., London
Pereira PM (2011) Avaliação do potencial de fungos na degradação do herbicida atrazina. Dissertation, Fundação Oswaldo Cruz, Instituto Nacional de Controle de Qualidade em Saúde
Pereira PM, Teixeira RSS, Oliveira MAL, Silva M, Santana VFL (2013) Optimized atrazine degradation by Pleurotus ostreatus INCQS 40310: an alternative for impact reduction of herbicides used in sugarcane crops. J Microb Biochem Technol S 12:9. https://doi.org/10.4172/1948-5948.S12-006
Petchluan P, Pukahuta C, Chaikong N (2014) Characterization of xylanase and cellulase from Lentinus polychrous Lev. LP-PT-1. Chiang Mai J Sci 41:1007–1019
Piscitelli A, Giardina P, Lettera V, Pezzella C, Sannia G, Faraco V (2011) Induction and transcriptional regulation of laccases in fungi. Curr Genomics 12:104–112. https://doi.org/10.2174/138920211795564331
Pizzul L, Castillo MdP, Stenstrom J (2009) Degradation of glyphosate and other pesticides by ligninolytic enzymes. Biodegradation 20:751–759. https://doi.org/10.1007/s10532-009-9263-1
Põldmaa K (2011) Tropical species of Cladobotryum and Hypomyces producing red pigments. Stud Mycol 68:1–34. https://doi.org/10.3114/sim.2011.68.01
Posada D, Buckley TR (2004) Model selection and model averaging in phylogenetics: advantages of akaike information criterion and bayesian approaches over likelihood ratio tests. Syst Biol 53:793–808. https://doi.org/10.1080/10635150490522304
Qi ZH, Meng J, Wang ZL, Sun HZ, Gong Y (2016) Antitumor effect of Ganoderma lipsiense extract on triple-negative breast cancer model mice and mechanism study. Chin J Integr Med 36:366–369
Qiao X, Huang W, Bian Y (2014) Effective removal of cadmium ions from a simulated gastrointestinal fluid by Lentinus edodes. Int J Environ Res Public Health 11:12486–12498. https://doi.org/10.3390/ijerph111212486
Reddy GVB, Joshi DK, Gold MH (1997) Degradation of chlorophenoxyacetic acids by the lignin-degrading fungus Dichomitus squalens. Microbiology 143:2353–2360. https://doi.org/10.1099/00221287-143-7-2353
Reis MR, Leão EU, Santos GR, Sarmento-Brum RBC, Gonçalves CG, Cardon CH, Silva DB (2013) Impacto de herbicidas em isolados de Trichoderma spp. Planta Daninha 31:419–426. https://doi.org/10.1590/S0100-83582013000200020
Rodrıguez E, Nuero O, Guillén F, Martınez AT, Martınez MJ (2004) Degradation of phenolic and non-phenolic aromatic pollutants by four Pleurotus species: the role of laccase and versatile peroxidase. Soil Biol Biochem 36(6):909–916. https://doi.org/10.1016/j.soilbio.2004.02.005
Ronquist F, Teslenko M, van der Mark P, Ayres DL, Darling A, Hohna S, Larget B, Liu L, Suchard MA, Huelsenbeck JP (2012) MrBayes 3.2: efficient Bayesian phylogenetic inference and model choice across a large model space. Syst Biol 61:539–542. https://doi.org/10.1093/sysbio/sys029
Sambrook J, Fritsch EF, Maniatis T (1989) Molecular cloning: a laboratory manual. Cold Spring Harbor Laboratory Press, New York
Sapieha-Waszkiewicz A, Marjańska-Cichoń B, Miętkiewski R (2003) The effect of pesticides used in apple orchards on entomopathogenic fungi in vitro. Electron J Pol Agric Univ (EJPAU) 6:10
Sasidhara R, Thirunalasundari T (2014) Phytochemicals and antioxidant potentials of Pleurotus djamor. J Chem Pharm Res 6:950–953
Schulz B, Segobye K (2016) 2,4-D transport and herbicide resistance in weeds. J Exp Bot 67:3177–3179. https://doi.org/10.1093/jxb/erw199
Seelan JS, Justo A, Nagy LG, Grand EA, Redhead SA, Hibbett D (2015) Phylogenetic relationships and morphological evolution in Lentinus, Polyporellus and Neofavolus, emphasizing southeastern Asian taxa. Mycologia 107:460–474. https://doi.org/10.3852/14-084
Senthilarasu G (2015) The lentinoid fungi (Lentinus and Panus) from Western Ghats, India. IMA Fungus 6:119–128. https://doi.org/10.5598/imafungus.2015.06.01.06
Serbent MP, Rebelo AM, Pinheiro A, Giongo A, Tavares LBB (2019) Biological agents for 2,4-dichlorophenoxyacetic acid herbicide degradation. Appl Microbiol Biotechnol 103:5065–5078. https://doi.org/10.1007/s00253-019-09838-4
Sharma SK, Atri NS (2013) Study on mycelial growth pattern of five wild Lentinus species. Eur J Appl Sci 5:71–75. https://doi.org/10.5829/idosi.ejas.2013.5.3.26313
Sharma V, Upadhyay R, Kamal S, Kumar S, Bihari Mohapatra K, Sharma M (2015) Characterization, cultivation, nutritional and antioxidant properties of the culinary edible mushroom Lentinus connatus. Sydowia 67:167–174. https://doi.org/10.12905/0380.sydowia67-2015-0167
Short KA, Doyle JD, King RJ, Seidler RJ, Stotzky G, Olsen RH (1991) Effects of 2,4-dichlorophenol, a metabolite of a genetically engineered bacterium, and 2,4-dichlorophenoxyacetate on some microorganism-mediated ecological processes in soil. Appl Environ Microbiol 57:412–418. https://doi.org/10.1128/AEM.57.2.412-418.1991
Silva TM, Stets MI, Mazzetto AM, Andrade FD, Pileggi SAV, Fávero PR, Cantú MD, Carrilho E, Carneiro PIB, Pileggi M (2007) Degradation of 2,4-D herbicide by microorganisms isolated from Brazilian contaminated soil. Braz J Microbiol 38:522–525. https://doi.org/10.1590/S1517-83822007000300026
Sing NN, Zulkharnain A, Roslan HA, Assim Z, Husaini A (2014) Bioremediation of PCP by Trichoderma and Cunninghamella strains isolated from sawdust. Braz Arch Biol Technol 57:811–820. https://doi.org/10.1590/S1516-8913201402852
Singdevsachan SK, Patra JK, Tayung K, Thatoi H (2017) Chemical constituents, antioxidative and antibacterial properties of medicinal mushrooms collected from Similipal Biosphere Reserve, Odisha, India. Proc Natl Acad Sci India B Biol Sci 87:559–570. https://doi.org/10.1007/s40011-015-0574-1
Singh H (2006) Mycoremediation: fungal bioremediation. Wiley, Hoboken
Sliva D (2010) Medicinal mushroom Phellinus linteus as an alternative cancer therapy. Exp Ther Med 1:407–411. https://doi.org/10.3892/etm_00000063
Son H, Lee J, Lee Y-W (2012) Mannitol induces the conversion of conidia to chlamydospore-like structures that confer enhanced tolerance to heat, drought, and UV in Gibberella zeae. Microbiol Res 167:608–615. https://doi.org/10.1016/j.micres.2012.04.001
Souza DF, Costa SC, Dacome AS, Souza CGM, Bracht A, Peralta RM (2011) Pentachlorophenol removal by Pleurotus pulmonarius in submerged cultures. Braz Arch Biol Technol 54:357–362. https://doi.org/10.1590/S1516-89132011000200018
Stalpers J (2007) The resupinate Russulales species database. Westerdijk Fungal Biodiversity Institute. http://www.cbs.knaw.nl/russulales/. Accessed 03 Oct 2019
Stamatakis A (2014) RAxML version 8: a tool for phylogenetic analysis and post-analysis of large phylogenies. Bioinformatics 30:1312–1313. https://doi.org/10.1093/bioinformatics/btu033
Stevanovic J, Stanimirovic Z, Simeunovic P, Lakic N, Radovic I, Sokovic M, Griensven L (2018) The effect of Agaricus brasiliensis extract supplementation on honey bee colonies. An Acad Bras Cienc 90:219–229. https://doi.org/10.1590/0001-3765201820150182
Tahir L, Ali MI, Zia M, Atiq N, Hasan F, Ahmed S (2013) Production and characterization of esterase in Lentinus tigrinus for degradation of polystyrene. Pol J Microbiol 62:101–108. https://doi.org/10.33073/pjm-2013-015
Tang YJ, Zhong JJ (2004) Modeling the kinetics of cell growth and ganoderic acid production in liquid static cultures of the medicinal mushroom Ganoderma lucidum. Biochem Eng J 21:259–264. https://doi.org/10.1016/j.bej.2004.06.008
Thaung MM (2007) A preliminary survey of macromycetes in Burma. Australas Mycol 26:16–36
Tsujiyama S, Muraoka T, Takada N (2013) Biodegradation of 2,4-dichlorophenol by shiitake mushroom (Lentinula edodes) using vanillin as an activator. Biotechnol Lett 35:1079–1083. https://doi.org/10.1007/s10529-013-1179-5
Umeo SH, Souza GP, Rapachi PM, Garcia DM, Paccola-Meirelles LD, Valle JS, Colauto NB, Linde GA (2015) Screening of basidiomycetes in submerged cultivation based on antioxidant activity. Genet Mol Res GMR 14:9907–9914. https://doi.org/10.4238/2015
UN, United Nations (United Nations World Water Assessment Programme) (2018) WWAP The United Nations World Water Development Report 2018: nature-based solutions for water. http://unesdoc.unesco.org/images/0026/002614/261424e.pdf. Accessed 07 Oct 2019
Valle JS, Vandenberghe LP, Santana TT, Almeida PH, Pereira AM, Linde GA, Colauto NB, Soccol CR (2014) Optimum conditions for inducing laccase production in Lentinus crinitus. Genet Mol Res GMR 13:8544–8551. https://doi.org/10.4238/2014
Valli K, Gold MH (1991) Degradation of 2,4-dichlorophenol by the lignin-degrading fungus Phanerochaete chrysosporium. J Bacteriol 173:345–352. https://doi.org/10.1128/jb.173.1.345-352.1991
Venâncio C, Pereira R, Freitas AC, Rocha-Santos TAP, da Costa JP, Duarte AC, Lopes I (2017) Salinity induced effects on the growth rates and mycelia composition of basidiomycete and zygomycete fungi. Environ Pollut 231:1633–1641. https://doi.org/10.1016/j.envpol.2017.09.075
Vroumsia T, Steiman R, Seiglemurandi F, Benoitguyod J (2005) Fungal bioconversion of 2,4-dichlorophenoxyacetic acid (2,4-D) and 2,4-dichlorophenol (2,4-DCP). Chemosphere 60:1471–1480. https://doi.org/10.1016/j.chemosphere.2004.11.102
Wang Z, Binder M, Dai YC, Hibbett DS (2004) Phylogenetic relationships of Sparassis inferred from nuclear and mitochondrial ribosomal DNA and RNA polymerase sequences. Mycologia 96:1015–1029. https://doi.org/10.2307/3762086
Wang Y, Wei D, Li K, Wang B, Shi L, Zhang G, Wang X, Du B, Wei Q (2015) Response of extracellular polymeric substances to the toxicity of 2,4-dichlorophenol in aerobic granular sludge system: production and interaction mechanism. RSC Adv 5:33016–33022. https://doi.org/10.1039/C5RA03076E
Wang Y, Li H, Feng G, Du L, Zeng D (2017) Biodegradation of diuron by an endophytic fungus Neurospora intermedia DP8-1 isolated from sugarcane and its potential for remediating diuron-contaminated soils. PLoS ONE 12:e0182556. https://doi.org/10.1371/journal.pone.0182556
Westphalen MC, Silveira RMB (2013) Pileate polypores from Araucaria forests in Southern Brazil. Hoehnea 40:77–86. https://doi.org/10.1590/S2236-89062013000100003
Wisniewski AC, Almeida MAL, Palma MB, Tavares LBB (2010) Produção de enzimas amilolíticas por Macrocybe titans em resíduo do processamento de cerveja. Rev Bras Bioci 8:285–293
Yadav JS, Reddy C (1993) Mineralization of 2,4-Dichlorophenoxyacetic Acid (2,4-D) and mixtures of 2,4-D and 2,4,5-Trichlorophenoxyacetic acid by Phanerochaete chrysosporium. Appl Environ Microbiol 59:2904–2908. https://doi.org/10.1128/AEM.59.9.2904-2908.1993
Yakup Arıca M, Bayramoğlu G (2005) Cr(VI) biosorption from aqueous solutions using free and immobilized biomass of Lentinus sajor-caju: preparation and kinetic characterization. Colloid Surf A Physicochem Eng Asp 253:203–211. https://doi.org/10.1016/j.colsurfa.2004.11.012
Yildirim N, Tanyol M, Dere T, Cumurcu A, Yildiz A (2012) The investigation on physic-chemical parameters of the textile effluents after treatment by white rot fungus Pleurotus djamor. New Biotechnol 29:S184. https://doi.org/10.1016/j.nbt.2012.08.515
Zabaloy MC, Garland JL, Gómez MA (2008) An integrated approach to evaluate the impacts of the herbicides glyphosate, 2,4-D and metsulfuron-methyl on soil microbial communities in the Pampas region, Argentina. Appl Soil Ecol 40:1–12. https://doi.org/10.1016/j.apsoil.2008.02.004
Zhao RL, He YM (2018) Network pharmacology analysis of the anti-cancer pharmacological mechanisms of Ganoderma lucidum extract with experimental support using Hepa1-6-bearing C57 BL/6 mice. J Ethnopharmacol 210:287–295. https://doi.org/10.1016/j.jep.2017.08.041
Zilly A, Santos Bazanella GC, Helm CV, Araújo CAV, de Souza CGM, Bracht A, Peralta RM (2012) Solid-State bioconversion of passion fruit waste by white-Rot fungi for production of oxidative and hydrolytic enzymes. Food Bioprocess Technol 5:1573–1580. https://doi.org/10.1007/s11947-011-0532-8
Acknowledgements
The authors thank Aristóteles Góes-Neto for facilitating the sequencing process. The authors are thankful to the Coordination for the Improvement of Higher Education Personnel (CAPES) for financial support. The author L.B.B. Tavares is a fellowship holder of the National Council for Scientific and Technological Development (CNPq). The author E.R. Drechsler-Santos is supported by CNPq (processo n. 311158/2018-8).
Funding
This research is part of the MIND.Funga Project: https://mindfunga.ufsc.br.
Author information
Authors and Affiliations
Corresponding author
Ethics declarations
Conflict of interest
The authors declare that they have no conflict of interest.
Ethical approval
This article does not contain any studies with human participants or animals performed by any of the authors.
Additional information
Communicated by M. Abbaspour.
Electronic supplementary material
Below is the link to the electronic supplementary material.
Rights and permissions
About this article
Cite this article
Serbent, M.P., Guimarães, D.K.S., Drechsler-Santos, E.R. et al. Growth, enzymatic production and morphology of the white-rot fungi Lentinus crinitus (L.) Fr. upon 2,4-D herbicide exposition. Int. J. Environ. Sci. Technol. 17, 2995–3012 (2020). https://doi.org/10.1007/s13762-020-02693-1
Received:
Revised:
Accepted:
Published:
Issue Date:
DOI: https://doi.org/10.1007/s13762-020-02693-1